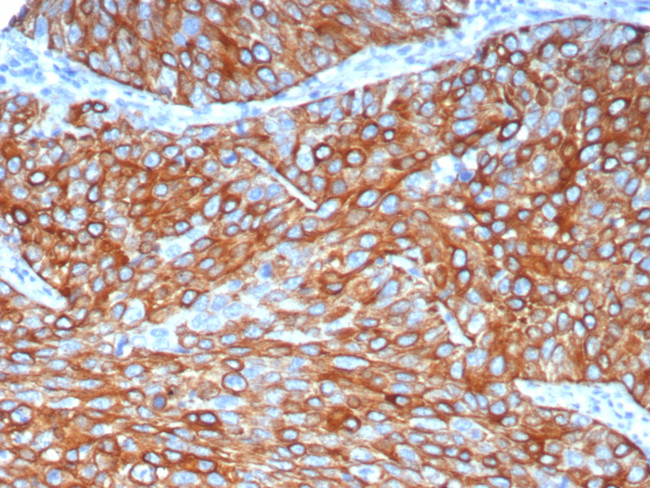
Cytokeratin 6A (KRT6A) (Basal Cell Marker) Antibody in Immunohistochemistry (Paraffin) (IHC (P))

Search
NeoBiotechnologies
Cytokeratin 6A (KRT6A) (Basal Cell Marker) Recombinant Rabbit Monoclonal Antibody (KRT6/8120R)
{{$productOrderCtrl.translations['antibody.pdp.commerceCard.promotion.promotions']}}
{{$productOrderCtrl.translations['antibody.pdp.commerceCard.promotion.viewpromo']}}
{{$productOrderCtrl.translations['antibody.pdp.commerceCard.promotion.promocode']}}: {{promo.promoCode}} {{promo.promoTitle}} {{promo.promoDescription}}. {{$productOrderCtrl.translations['antibody.pdp.commerceCard.promotion.learnmore']}}
图: 1 / 1
Cytokeratin 6A (KRT6A) (Basal Cell Marker) Antibody (3853-RBM10-P1ABX) in IHC (P)

产品信息
3853-RBM10-P1ABX
种属反应
宿主/亚型
Expression System
分类
类型
克隆号
抗原
偶联物
形式
浓度
纯化类型
保存液
内含物
保存条件
运输条件
靶标信息
Keratins 6 and 16 are expressed in keratinocytes, which are undergoing rapid turnover in the suprabasal region (also known as hyperproliferation-related keratins). Keratin 6 is found in hair follicles, suprabasal cells of a variety of internal stratified epithelia, in epidermis, in both normal and hyperproliferative situations. Epidermal injury results in activation of keratinocytes which express CK6 and CK16. CK6 is strongly expressed in about 75% of head and neck squamous cell carcinomas. Expression of CK6 is particularly associated with differentiation.
仅用于科研。不用于诊断过程。未经明确授权不得转售。
篇参考文献 (0)
生物信息学
蛋白别名: CK-6A; CK-6D; cytokeratin 6A; cytokeratin 6C; cytokeratin 6D; Cytokeratin-6A; cytokeratin-6C; Cytokeratin-6D; cytokeratin-6E; K6A; kamp-keratin derived antimicrobial peptide; KDAMP; keratin 6A, , type II; keratin 6A, type II; keratin K6h; keratin, epidermal type II, K6A; Keratin, type II cytoskeletal 6A; Keratin-6A; keratin-6C; type-II keratin Kb12; Type-II keratin Kb6
基因别名: CK-6C; CK-6E; CK6A; CK6C; CK6D; K6A; K6C; K6D; KRT6A; KRT6C; KRT6D; PC3
UniProt ID: (Human) P02538
Entrez Gene ID: (Human) 3853